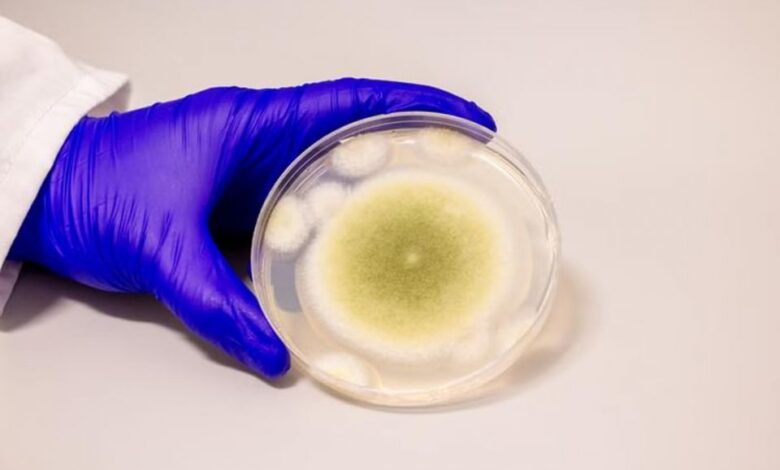

Ο μύκητας «κατάρα της μούμιας» μπορεί να αποτελέσει φάρμακο κατά του καρκίνου σύμφωνα με μελέτη
Ένας μύκητας που βρέθηκε σε αρχαίους αιγυπτιακούς τάφους πιστεύεται ότι μπορεί να αποτελέσει ένα πολύτιμο νέο εργαλείο στην καταπολέμηση του καρκίνου.
Ο μύκητας Aspergillus flavus, ο οποίος απέκτησε το παρατσούκλι «η κατάρα της μούμιας» λόγω της πιθανής σύνδεσής του με τον θάνατο αρχαιολόγων που ανέσκαψαν διάσημους τάφους όπως αυτός του Τουταγχαμών, αφήνει υποσχέσεις για την καταπολέμηση καρκίνων όπως η λευχαιμία, σύμφωνα με μια νέα μελέτη που δημοσιεύθηκε στο περιοδικό Nature Chemical Biology από μια ομάδα επιστημόνων με επικεφαλής το Πανεπιστήμιο της Πενσιλβάνια στις ΗΠΑ.
«Οι μύκητες μάς έδωσαν την πενικιλίνη», ανακοίνωσε η Sherry Gao, αναπληρώτρια καθηγήτρια χημικής και βιομοριακής μηχανικής και βιομηχανικής στο Πανεπιστήμιο της Πενσυλβανίας και επικεφαλής συγγραφέας της μελέτης. «Αυτά τα αποτελέσματα δείχνουν ότι υπάρχουν πολλά ακόμη φάρμακα που προέρχονται από φυσικά προϊόντα και δεν έχουν ανακαλυφθεί ακόμα».
Δράση κατά των λευχαιμικών κυττάρων
Κατά τη διάρκεια της έρευνάς τους, οι επιστήμονες απομόνωσαν μια νέα κατηγορία μορίων που προέρχονται από τον μύκητα, τις ασπεριγιμυκίνες, και τις δοκίμασαν σε κοινές μορφές καρκίνου σε κύτταρα του μαστού, του ήπατος και των πνευμόνων, αναφέρει ο Independent.
Ακόμη και χωρίς τροποποίηση, δύο από τις τέσσερις ασπεριγιμυκίνες που χρησιμοποιήθηκαν στο πείραμα είχαν «ισχυρή» δράση κατά των λευχαιμικών κυττάρων, σύμφωνα με το πανεπιστήμιο. Ενώ μια άλλη παραλλαγή, στην οποία οι επιστήμονες πρόσθεσαν ένα μόριο λιπιδίου, είχε εξίσου καλή απόδοση με τα εγκεκριμένα φάρμακα για τη λευχαιμία κυταραβίνη και η δαουνορουβικίνη.
Ο μύκητας Aspergillus flavus μπορεί να προκαλέσει λοιμώξεις των πνευμόνων, ειδικά σε άτομα με εξασθενημένο ανοσοποιητικό σύστημα
Bella Ciervo
Οι ερευνητές πιστεύουν ότι αυτά τα μόρια, που δημιουργήθηκαν μέσα στον κυτταρικό μηχανισμό του μύκητα και στη συνέχεια τροποποιήθηκαν από τους συγγραφείς της μελέτης, εμποδίζουν ορισμένους από τους μηχανισμούς της κυτταρικής διαίρεσης, σταματώντας την ανεξέλεγκτη κυτταρική ανάπτυξη που προκαλεί τον καρκίνο.
«Τα καρκινικά κύτταρα διαιρούνται ανεξέλεγκτα», πρόσθεσε η Gao. «Αυτές οι ενώσεις εμποδίζουν το σχηματισμό μικροσωληνίσκων, οι οποίοι είναι απαραίτητα για την κυτταρική διαίρεση».



